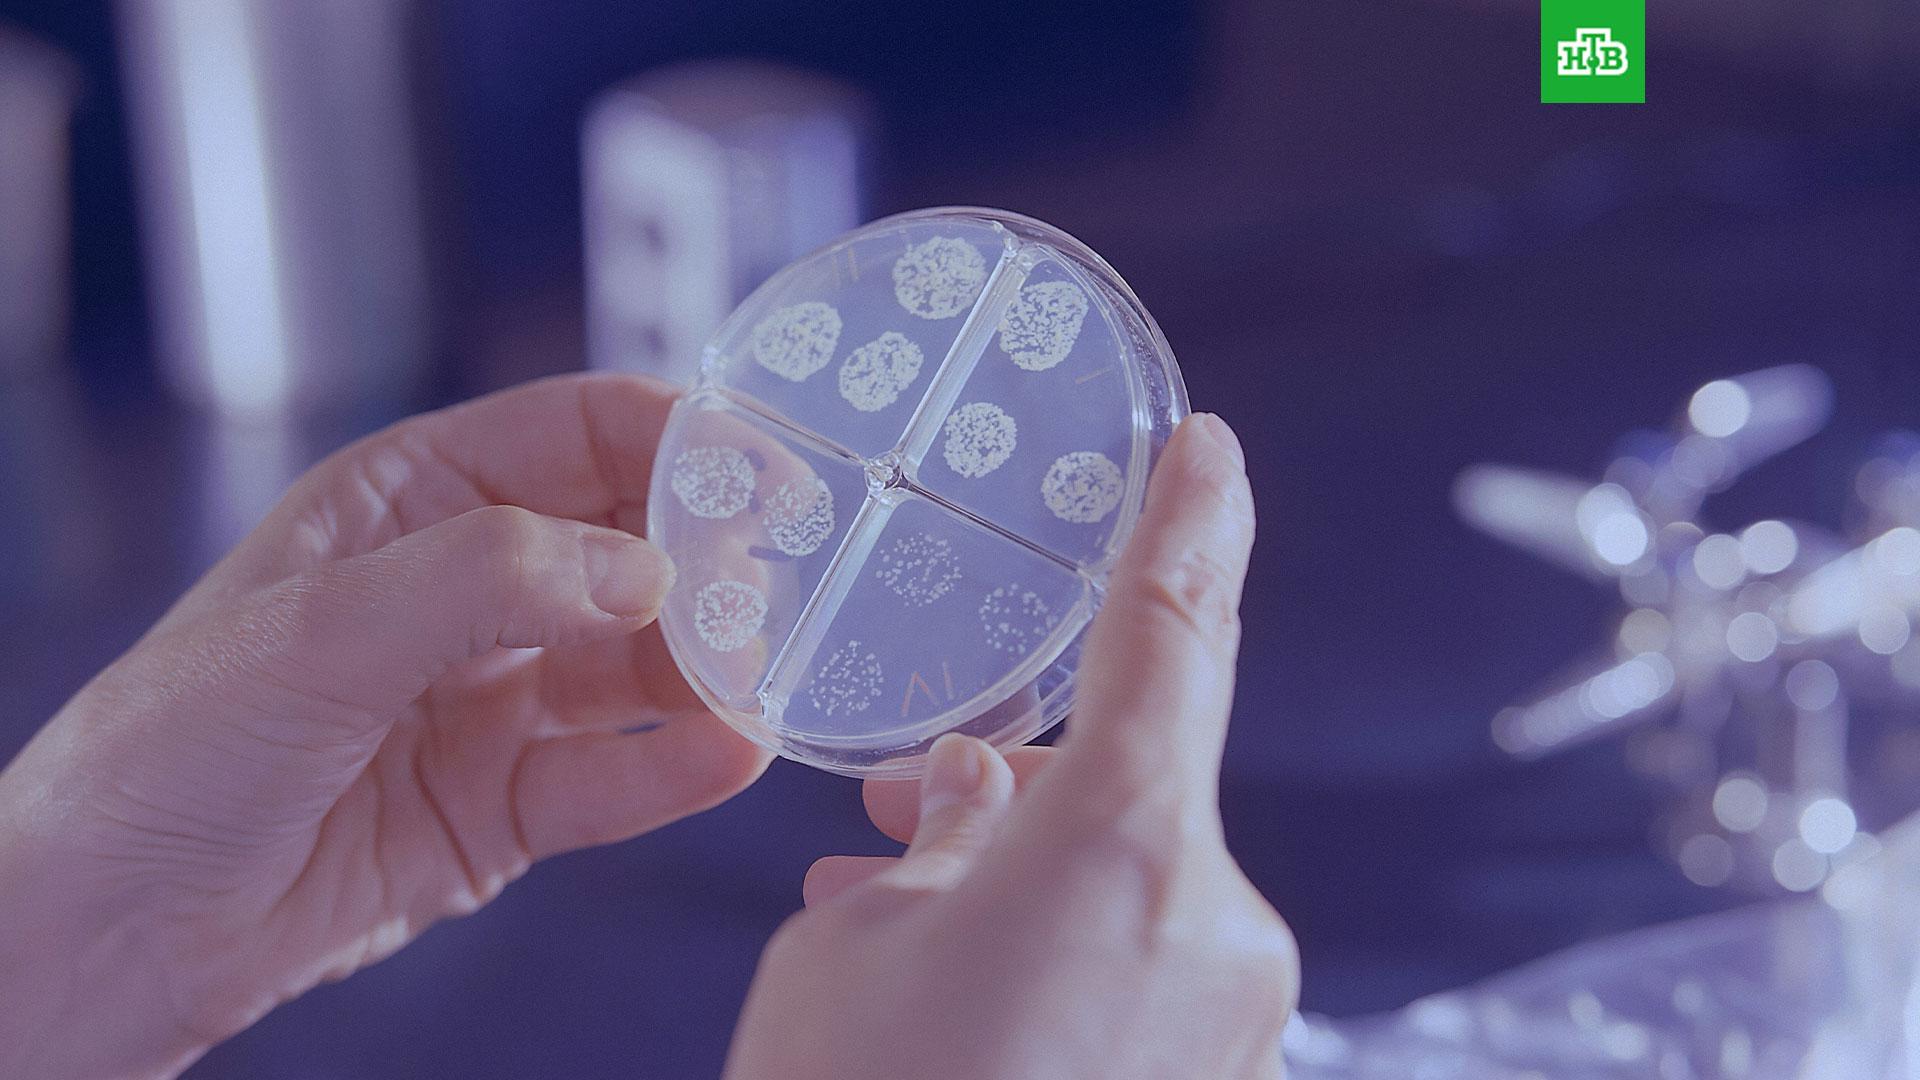

В Роспотребнадзоре отреагировали на сообщения о том, что россияне жалуются на кашель с кровью и высокую температуру из-за загадочного вируса.
В Роспотребнадзоре сообщили, что специалисты «взяли на контроль сообщения о случаях заболевания якобы неизвестным вирусом».
Ранее СМИ сообщили, что в России произошла вспышка вируса, который вызывает сильнейшие приступы кашля с кровью и высокую температуру. При этом утверждалось, что врачи не могут сказать, что это за вирус, и ставят заболевшим диагноз «неуточненная острая инфекция верхних дыхательных путей».